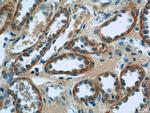
SSTR2 Antibody in Immunohistochemistry (Paraffin) (IHC (P))

Search
Proteintech
SSTR2 Polyclonal Antibody
{{$productOrderCtrl.translations['antibody.pdp.commerceCard.promotion.promotions']}}
{{$productOrderCtrl.translations['antibody.pdp.commerceCard.promotion.viewpromo']}}
{{$productOrderCtrl.translations['antibody.pdp.commerceCard.promotion.promocode']}}: {{promo.promoCode}} {{promo.promoTitle}} {{promo.promoDescription}}. {{$productOrderCtrl.translations['antibody.pdp.commerceCard.promotion.learnmore']}}
产品信息
20404-1-AP
种属反应
宿主/亚型
分类
类型
抗原
偶联物
形式
浓度
规格
纯化类型
保存液
内含物
保存条件
运输条件
产品详细信息
Immunogen sequence: MDMADEPLN GSHTWLSIPF DLNGSVVSTN TSNQTEPYYD LTSNAVLTFI YFVVCIIGLC G (1-60 aa encoded by BC019610)
靶标信息
SSTR2 (somatostatin receptor 2) is a member of the superfamily of receptors having seven transmembrane segments and is expressed in highest levels in the cerebrum and kidney. Somatostatin acts at many sites to inhibit the release of many hormones and other secretory proteins. The receptor is coupled via pertussis toxin sensitive G proteins to inhibit adenylyl cyclase.
仅用于科研。不用于诊断过程。未经明确授权不得转售。
生物信息学
蛋白别名: somatostatin receptor; somatostatin receptor 2a; Somatostatin receptor type 2; SRIF-1; SS-2-R; SS2-R; SS2R; SSR2; SSTR2A; unnamed protein product
基因别名: Smstr-2; Smstr2; SST2; SSTR-2; SSTR2
UniProt ID: (Human) P30874, (Mouse) P30875
Entrez Gene ID: (Human) 6752, (Mouse) 20606